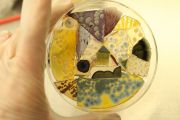
Ground-dwellers-Maru-Garcia

MARU GARCIA
Artist Statement / Bio
Maru García is a Mexican, LA-based artist/chemist working across art + science + environment.
Her methodology combines laboratory and fieldwork tools from her background in plant chemistry and the pharmaceutical industry. Her use of media includes research, installations, performance, sculpture, and video, usually with the presence of organic matter to help understand the biological processes occurring in complex systems. Her areas of interest are biosystems, multispecies relations, and the capacity of living organisms (including humans) to act as remediators in contaminated sites. Her work highlights the importance of eco-aesthetics, in which relations are proposed as ways of building cultures of regeneration. At the same time, she questions the ways science and technology have influenced humans and more-than-humans within the natural world.
Maru has participated in conferences, solo and group exhibitions in North America, Europe, and Asia. She was an artist in residence in the National Center of Genetic Resources in Mexico and has received awards from the New York Foundation for the Arts ‘Anonymous Was a Woman Environmental Art Grant’, the California Environmental Protection Agency (CalEPA) Social Justice Grant, the California Arts Council, Los Angeles Sustainability Collaborative, Clifton Webb Scholarship for the Arts, and Fundación Jumex. She collaborated with the Art-Sci Center and Counterforce Lab at UCLA and was a 2020- 2021 Sci-Art Ambassador for Supercollider. She worked at the Getty Research Institute in the 2019-2020 Scholar program titled “Art and Ecology” and was a 2021-2022 artist in residence at 18th Street Arts Center. Currently, she is a Getty Foundation grant recipient for the exhibition “Sink: places we call home” Self Help Graphics & Art, to be presented in the Pacific Standard Time Art x Science x LA in 2024. She is an Associate Research Scientist in Mineral Sciences at the Natural History Museum of Los Angeles County. She is the founder of Biomedia Studio and Prospering backyards. Maru holds an MFA in Design & Media Arts from UCLA as well as an MS in Biotechnology and a BS in Chemistry both from Tecnológico de Monterrey, México.
Artist Essentials
- Contact Artist
- Artist Website
- Phone: 3236273915
Azusa, California
United States
Northern America
Artist Social
- Video: https://vimeo.com/465237734
- Instagram: https://www.instagram.com/marugfe/